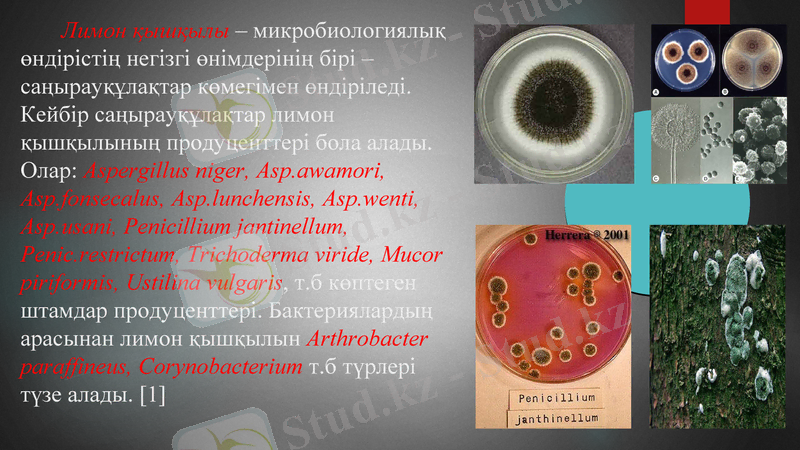
Slide 6

Лимон қышқылын алудың терең дақылдау әдісі: микробиологиялық технология мен өндірістік параметрлер



Тақырыбы: Лимон қышқылын алудың тереңдік әдiсі.
Тексерген:

Жоспар:
Кіріспе
Лимон және оның пайдасы
Лимон қышқылы
Лимон қышқылын алу технологиясы
Лимон қышқылын алудың тереңдік әдісі
Қорытынды
Пайдаланылған әдебиеттер

Органикалық қышқылдар азық-түлік, фармацевтикалық, химиялық, тоқыма, тері өңдеу, металлургия және басқа да өндіріс салаларында қолданылады. Органикалық қышқылдарды химиялық және микробиологиялық тәсілмен өндіреді. Химиялық жолмен өндіргенде техникада қолданықа ие болатын мұнайдың химиялық шикізатына, ағаштың құрғақ ажырату өнімдерінен бөліп алады. Микробиологиялық тәсілмен 50-ден астам органикалық қышқылдар алынады. Олар: лимон, глюкон, кетоглюкон және итакон қышқылдары. Химиялық және микробиологиялық тәсілдермен сүт, салицил, сірке қышқылдары өндіріледі, алма қышқылы - химиялық жолмен алынады. [1]

Лимон бізге сонау Үндістан мен Қытай жерлерінен келген. Лимон - жыл бойы жасыл болып тұратын ағаштың жемісі. Оның құрамында пектин, эфир майлары, биофлавоноидтар бар. Лимон асқазандағы қорытуға көмектесетін заттардың бөлінуіне әсер етіп, ағзаға темір мен кальцийдің сіңіруін жеңілдететін энзимдарды бөледі. Өзі қышқыл болғанына қарамастан, ол асқазан суларының қышқылдығын төмендетеді. Әрине лимон құрамындағы С дәрумені жайлы айтпай қоймасқа болмайды. Ол жалпы иммунды жүйені жақсартып, түрлі ауруларға тосқауыл болады. Лимон ағзадан қажет емес кір-қоқыстарды шығаруға да көмектеседі. Мысалы ұзақ уақыт дәрі, антибиотик қабылдасаңыз, лимонның көмегімен бауырыңызды улы заттардан тазартсаңыз болады. Лимон шырыны мен қабығы антисептикалық қасиетке ие. Онымен жараларды сүртіп, ерітіндісімен тамақ шайса болады. Лимон қан құрамындағы холестерин деңгейін төмендетіп, тәбетті ашады. [1]

Лимон қышқылы - микробиологиялық өндірістің негізгі өнімдерінің бірі - саңырауқұлақтар көмегімен өндіріледі. Кейбір саңырауқұлақтар лимон қышқылының продуценттері бола алады. Олар: Aspergillus niger, Asp. awamori, Asp. fonsecalus, Asp. lunchensis, Asp. wenti, Asp. usani, Penicillium jantinellum, Penic. restrictum, Trichoderma viride, Mucor piriformis, Ustilina vulgaris, т. б көптеген штамдар продуценттері. Бактериялардың арасынан лимон қышқылын Arthrobacter paraffineus, Corynobacterium т. б түрлері түзе алады. [1]

Лимон қышқылын алу технологиясы

Қанттың лимон қышқылына айналуында зең саңырауқұлақтары, оның ішінде аспергиллус нигер негізгі роль атқарады. Сондықтан бұл микроорганизм техникалық жолмен қанттан лимон қышқылын алуда кеңінен қолданылады. Соңғы кездерге дейін лимон қышқылы лимон жемісінен алынатын. Онда 7-9%-тей лимон қышқылы болады. Едәуір мөлшерде лимон кышқылын өндіру үшін көп мөлшерде лимон жемісі қажет болар еді және лимон қышқылын бұлай өндіру өнеркәсіп үшін экономикалық жағынан тиімсіз. Сондықтан да ғылым бүл мәселені микроорганизмдерді пайдалана отырып шешу керектігін үсынды. Лимон қышқылын алу үшін алдымен аспергиллус нигерді қүрамында 20% қанты бар, 0, 3% азот қышқыл аммоний тұзы бар қоректік ортада +30-32°-та өсіреді. Екі тәуліктен кейін бұл ортаның бетінде саңырауқүлақ қалың қыртыс түзіп өседі. Осы кезде оның астындағы коректік ортаны ағызып алады да саңырауқүлақты кайнатылып суытылған сумен жуады. Осы ыдысқа енді таза, алдын ала қайнатылған қүрамында қоректік түздары жоқ таза қант ерітіндісін құяды. Осы кезде саңырауқұлақ қанттан лимон қышқылын тез арада түзе бастайды. Мүндағы ашыту үшін салынған қанттың 50-60%-тейі лимон қышқылына айналады. Бұдан әрі оны тазартады да техникалық қажетке жұмсайды. Лимон қышқылымен бірге ерітіндіде көбінесе кымыздық қышқылы да түзіледі. [2]

Лимон қышқылы өндірісінің микробиологиялық синтез технологиясының негізгі сатылары: 1. егіс материалын алу; 2. ферментация процесіне мелассалы шикізаты дайындау; 3. ауаны залалсыздау және дайындау; 4. ферментация; 5. мицелия - продуцентінің биомассасын бөлу. [2]

Ферментация процесін бақылау барысында Aspergillus niger-дің мутантты штамы алынған. Бұл штамм лимон қышқылын 4 есе артық түзеді. Клеткалардың иммобилизацияланған түрлері де қолданылады. Aspergillus niger клеткаларын Са-альгинат геліне енгізеді. Үздіксіз лимон қышқылын өндіру мақсатында реакторда өсіреді. Қолайлы ортада максималды көлемді өнімділікті рН 2, 2-2, 3 жағдайында реактордың өнім беру қарқындылығы өседі. Өндіріс жағдайында лимон қышқылын: 1) Беткі дақылдау; 2) Тереңдік дақылдау; 3) Қатты фазалы ферментация; 4) Koji процесі. [2]

- Іс жүргізу
- Автоматтандыру, Техника
- Алғашқы әскери дайындық
- Астрономия
- Ауыл шаруашылығы
- Банк ісі
- Бизнесті бағалау
- Биология
- Бухгалтерлік іс
- Валеология
- Ветеринария
- География
- Геология, Геофизика, Геодезия
- Дін
- Ет, сүт, шарап өнімдері
- Жалпы тарих
- Жер кадастрі, Жылжымайтын мүлік
- Журналистика
- Информатика
- Кеден ісі
- Маркетинг
- Математика, Геометрия
- Медицина
- Мемлекеттік басқару
- Менеджмент
- Мұнай, Газ
- Мұрағат ісі
- Мәдениеттану
- ОБЖ (Основы безопасности жизнедеятельности)
- Педагогика
- Полиграфия
- Психология
- Салық
- Саясаттану
- Сақтандыру
- Сертификаттау, стандарттау
- Социология, Демография
- Спорт
- Статистика
- Тілтану, Филология
- Тарихи тұлғалар
- Тау-кен ісі
- Транспорт
- Туризм
- Физика
- Философия
- Халықаралық қатынастар
- Химия
- Экология, Қоршаған ортаны қорғау
- Экономика
- Экономикалық география
- Электротехника
- Қазақстан тарихы
- Қаржы
- Құрылыс
- Құқық, Криминалистика
- Әдебиет
- Өнер, музыка
- Өнеркәсіп, Өндіріс
Қазақ тілінде жазылған рефераттар, курстық жұмыстар, дипломдық жұмыстар бойынша біздің қор #1 болып табылады.



Ақпарат
Қосымша
Email: info@stud.kz